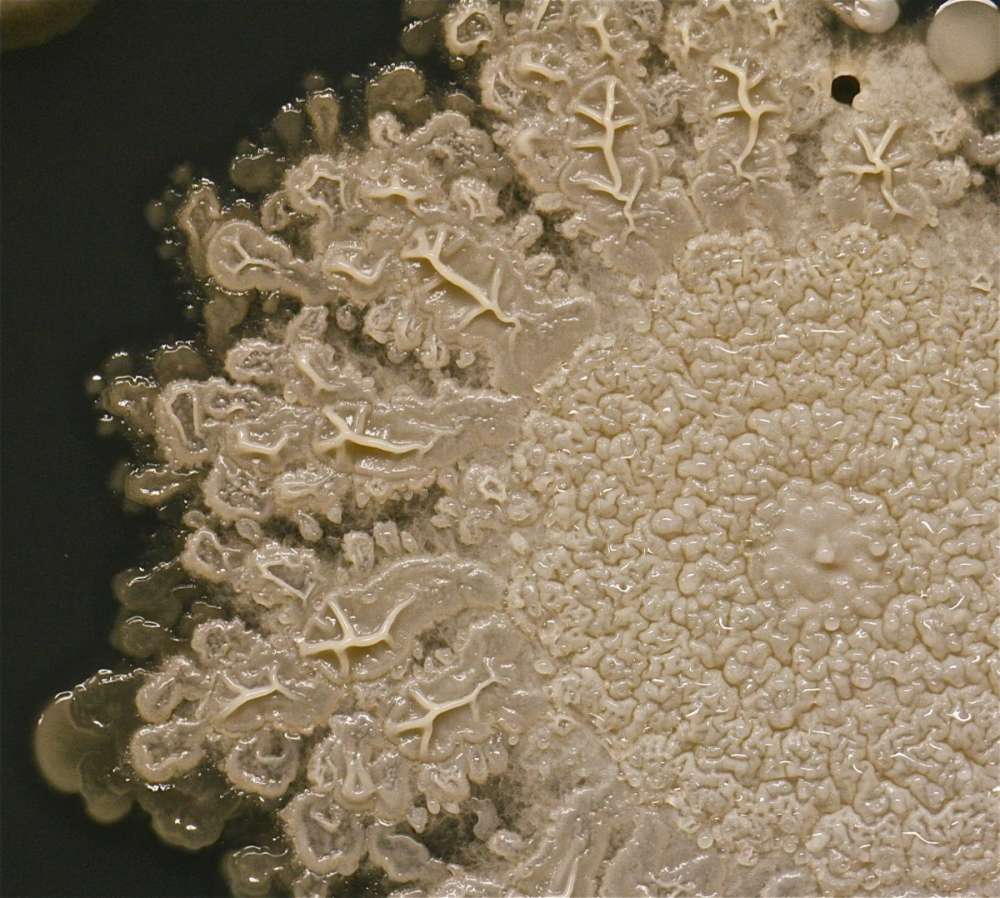
Вероятные причины гибели Земли

Вероятные причины гибели Земли
Атмосфера на нашей планете, расстояние до солнца и множество других невероятных совпадений привели к тому, что на Земле может существовать жизнь в том виде, как мы её знаем.

Всё это воспринимается нами как данность, и мы, спеша на работу или отдыхая за столиком в кафе, не находим ничего удивительного в нашем существовании.
Но всё хорошее когда-нибудь кончается. Однажды Земля станет непригодной для поддержания той жизни, которую мы знаем.
Может быть, этого не случится еще миллионы лет. Но астрофизика нам подсказывает, что катастрофа может произойти в любой момент.
И учёные нашли немало причин, по которым Земля может стать безжизненной.

Земля окружена магнитным полем, называемым магнитосферой, которая защищает нас от солнечного ветра.

Это поле создаётся благодаря вращению планеты, из-за которого жидкая железоникелевая оболочка (внешнее ядро) движется вокруг твердой металлической сердцевины (внутреннего ядра), образуя гигантский магнитный генератор.

Магнитосфера отклоняет энергетические частицы, испускаемые солнцем, изменяет их размер и форму.

Если ядро планеты остынет, то мы потеряем нашу магнитосферу – а также защиту от солнечного ветра, из-за чего он постепенно разнесёт атмосферу Земли по всему космосу.

Марс, у которого когда-то была вода и атмосфера, несколько миллионов лет назад постигла именно такая участь, и он превратился в сухой и безжизненный мир, каким мы его знаем теперь.


Солнце, а особенно наше расстояние до него – это, пожалуй, самый важный фактор, благодаря которому стало возможно существование жизни.

Однако Солнце – звезда. А звёзды умирают.

Прямо сейчас Солнце находится в середине своего жизненного пути, постоянно превращая водород в гелий при помощи термоядерных реакций.

Но это не может длиться вечно. Через несколько миллиардов лет водород в ядре Солнца закончится, и оно начнёт перерабатывать гелий.

Из-за того, что переработка гелия даёт гораздо больше энергии, Солнце начнёт расширяться, и, возможно – притягивать Землю к себе.

Мы сгорим и испаримся.

Либо так, либо расширение солнца напротив, оттолкнёт Землю, она сойдет со своей орбиты и будет обречена скитаться по космосу как планета-странник – мёртвым куском холодного камня.

В космосе немало планет, которые перемещаются по нему свободно, а не вращаются вокруг звезды. Планеты достаточно часто оказываются выкинуты из своих звёздных систем во время их формирования.

Недавние расчёты показывают, что количество планет-странников в Млечном Пути превосходит количество звёзд в 100 000 раз.

Одна из таких планет может приблизиться к Земле и опасно дестабилизировать её орбиту.

Или бродячая планета может столкнуться с Землёй. Причём такое уже случалось – около 4,5 млн. лет назад маленькая планета столкнулась с более крупной, что сформировало Землю и Луну такими, как мы их знаем.

В Голливуде очень любят такие сценарии.

Камни из космоса могут быть очень разрушительными – уничтожил же один из них динозавров. Хотя, конечно, для того, чтобы уничтожить планету полностью нужно гораздо больше астероидов.

Но это всё равно может произойти. Например, в течение сотен миллионов лет с момента формирования Земли астероиды сталкивались с ней очень часто. Удары были так сильны, что океаны кипели годами, а температура воздуха была выше 500 градусов по Цельсию. Жизнь на Земле тогда была одноклеточной, и была представлена в виде особо жаростойких микробов. Большая часть современных форм жизни такого бы не перенесла.


Чёрные дыры, пожалуй, вторая по популярности в Голливуде причина смерти планеты. Легко понять почему.

Они загадочные и пугающие. Даже само их название звучит жутковато.

Мы немногое знаем о чёрных дырах, зато знаем, что они настолько массивны, что даже свет не может вырваться за пределы их горизонта событий.

Также учёные знают, что существуют чёрные дыры, свободно путешествующие по космосу. Так что не исключено, что одна из них может навестить и Солнечную систему.

Если уж свет не может вырваться из чёрной дыры, то Земля уж точно не сможет. Есть две теории того, что произойдёт с планетой после того, как она пересечёт точку невозврата достаточно большой чёрной дыры. Менее крупная просто растянет (как говорят астрофизики, «спагеттифицирует») планету.

Некоторые физики говорят, что за горизонтом событий атомы будут растягиваться до тех пор, пока не уничтожаться полностью.

Иные – что мы попадём в другую часть вселенной, а то и в другое измерение.

Но, даже если чёрная дыра не затянет в себя Землю, то пройдя достаточно близко, она может вызвать землетрясения и другие стихийные бедствия или нарушить орбиту планеты, так что мы либо покинем солнечную систему, либо упадём на Солнце.

Всплески гамма-излучения (или просто гамма-всплески) – одни из самых мощных явлений во вселенной.

Многие из них – результат коллапса звезды во время её смерти. Один короткий всплеск может содержать больше энергии, чем Солнце может выработать за всю свою жизнь.

Такой мощный поток энергии может лишить Землю озонового слоя, сделав нас беззащитными перед опасным ультрафиолетовым излучением, и запустить механизм быстрого глобального похолодания.

Гамма-всплеск, попавший в Землю 440 млн. лет назад, мог быть причиной первого массового вымирания.

Но, к счастью, Дэвид Томпсон, заместитель руководитель проекта по наблюдению за гамма-излучением, сказал, что гамма-всплески на самом деле не очень опасны.

Он сказал, что шанс того, что Земля попадёт в поток гамма-всплеска, примерно равен «шансу того, что я встречу полярного медведя у себя в туалете».


Это то, что может уничтожить всю вселенную, не только Землю.

Суть вот в чём: неизвестная сила, называемая тёмной энергией, заставляет вселенную расширяться всё быстрее и быстрее.

Если расширение продолжится (что очень возможно), через 22 миллиарда лет межатомные связи ослабнут, и вся материя во вселенной постепенно рассеется в виде энергии.

Но если предположить, что Большого разрыва всё же не случится, то что может произойти после глобальной катастрофы, которую не переживёт человечество?

Вполне возможно, что выживут некоторые микробы, из которых потом вновь разовьётся жизнь.

Но если уничтожение будет абсолютным, то, на крайний случай, мы можем надеяться, что где-то во вселенной есть другая разумная жизнь, которая сможет отдать нам последние почести.

Источник

Всё это воспринимается нами как данность, и мы, спеша на работу или отдыхая за столиком в кафе, не находим ничего удивительного в нашем существовании.
Но всё хорошее когда-нибудь кончается. Однажды Земля станет непригодной для поддержания той жизни, которую мы знаем.
Может быть, этого не случится еще миллионы лет. Но астрофизика нам подсказывает, что катастрофа может произойти в любой момент.
И учёные нашли немало причин, по которым Земля может стать безжизненной.
1) Ядро планеты остынет

Земля окружена магнитным полем, называемым магнитосферой, которая защищает нас от солнечного ветра.

Это поле создаётся благодаря вращению планеты, из-за которого жидкая железоникелевая оболочка (внешнее ядро) движется вокруг твердой металлической сердцевины (внутреннего ядра), образуя гигантский магнитный генератор.

Магнитосфера отклоняет энергетические частицы, испускаемые солнцем, изменяет их размер и форму.

Если ядро планеты остынет, то мы потеряем нашу магнитосферу – а также защиту от солнечного ветра, из-за чего он постепенно разнесёт атмосферу Земли по всему космосу.

Марс, у которого когда-то была вода и атмосфера, несколько миллионов лет назад постигла именно такая участь, и он превратился в сухой и безжизненный мир, каким мы его знаем теперь.

2) Произойдёт расширение Солнца

Солнце, а особенно наше расстояние до него – это, пожалуй, самый важный фактор, благодаря которому стало возможно существование жизни.

Однако Солнце – звезда. А звёзды умирают.

Прямо сейчас Солнце находится в середине своего жизненного пути, постоянно превращая водород в гелий при помощи термоядерных реакций.

Но это не может длиться вечно. Через несколько миллиардов лет водород в ядре Солнца закончится, и оно начнёт перерабатывать гелий.

Из-за того, что переработка гелия даёт гораздо больше энергии, Солнце начнёт расширяться, и, возможно – притягивать Землю к себе.

Мы сгорим и испаримся.

Либо так, либо расширение солнца напротив, оттолкнёт Землю, она сойдет со своей орбиты и будет обречена скитаться по космосу как планета-странник – мёртвым куском холодного камня.

3) Земля столкнётся с планетой-странником
В космосе немало планет, которые перемещаются по нему свободно, а не вращаются вокруг звезды. Планеты достаточно часто оказываются выкинуты из своих звёздных систем во время их формирования.

Недавние расчёты показывают, что количество планет-странников в Млечном Пути превосходит количество звёзд в 100 000 раз.

Одна из таких планет может приблизиться к Земле и опасно дестабилизировать её орбиту.

Или бродячая планета может столкнуться с Землёй. Причём такое уже случалось – около 4,5 млн. лет назад маленькая планета столкнулась с более крупной, что сформировало Землю и Луну такими, как мы их знаем.

4) Земля столкнётся с астероидом
В Голливуде очень любят такие сценарии.

Камни из космоса могут быть очень разрушительными – уничтожил же один из них динозавров. Хотя, конечно, для того, чтобы уничтожить планету полностью нужно гораздо больше астероидов.

Но это всё равно может произойти. Например, в течение сотен миллионов лет с момента формирования Земли астероиды сталкивались с ней очень часто. Удары были так сильны, что океаны кипели годами, а температура воздуха была выше 500 градусов по Цельсию. Жизнь на Земле тогда была одноклеточной, и была представлена в виде особо жаростойких микробов. Большая часть современных форм жизни такого бы не перенесла.

5) Земля может сблизиться с блуждающей чёрной дырой

Чёрные дыры, пожалуй, вторая по популярности в Голливуде причина смерти планеты. Легко понять почему.

Они загадочные и пугающие. Даже само их название звучит жутковато.

Мы немногое знаем о чёрных дырах, зато знаем, что они настолько массивны, что даже свет не может вырваться за пределы их горизонта событий.

Также учёные знают, что существуют чёрные дыры, свободно путешествующие по космосу. Так что не исключено, что одна из них может навестить и Солнечную систему.

Если уж свет не может вырваться из чёрной дыры, то Земля уж точно не сможет. Есть две теории того, что произойдёт с планетой после того, как она пересечёт точку невозврата достаточно большой чёрной дыры. Менее крупная просто растянет (как говорят астрофизики, «спагеттифицирует») планету.

Некоторые физики говорят, что за горизонтом событий атомы будут растягиваться до тех пор, пока не уничтожаться полностью.

Иные – что мы попадём в другую часть вселенной, а то и в другое измерение.

Но, даже если чёрная дыра не затянет в себя Землю, то пройдя достаточно близко, она может вызвать землетрясения и другие стихийные бедствия или нарушить орбиту планеты, так что мы либо покинем солнечную систему, либо упадём на Солнце.
6) Земля будет уничтожена всплеском гамма-излучения

Всплески гамма-излучения (или просто гамма-всплески) – одни из самых мощных явлений во вселенной.

Многие из них – результат коллапса звезды во время её смерти. Один короткий всплеск может содержать больше энергии, чем Солнце может выработать за всю свою жизнь.

Такой мощный поток энергии может лишить Землю озонового слоя, сделав нас беззащитными перед опасным ультрафиолетовым излучением, и запустить механизм быстрого глобального похолодания.

Гамма-всплеск, попавший в Землю 440 млн. лет назад, мог быть причиной первого массового вымирания.

Но, к счастью, Дэвид Томпсон, заместитель руководитель проекта по наблюдению за гамма-излучением, сказал, что гамма-всплески на самом деле не очень опасны.

Он сказал, что шанс того, что Земля попадёт в поток гамма-всплеска, примерно равен «шансу того, что я встречу полярного медведя у себя в туалете».

7) Вселенная распадётся на части в своём последнем «Большом Разрыве»

Это то, что может уничтожить всю вселенную, не только Землю.

Суть вот в чём: неизвестная сила, называемая тёмной энергией, заставляет вселенную расширяться всё быстрее и быстрее.

Если расширение продолжится (что очень возможно), через 22 миллиарда лет межатомные связи ослабнут, и вся материя во вселенной постепенно рассеется в виде энергии.

Но если предположить, что Большого разрыва всё же не случится, то что может произойти после глобальной катастрофы, которую не переживёт человечество?

Вполне возможно, что выживут некоторые микробы, из которых потом вновь разовьётся жизнь.
Но если уничтожение будет абсолютным, то, на крайний случай, мы можем надеяться, что где-то во вселенной есть другая разумная жизнь, которая сможет отдать нам последние почести.

Источник


Комментариев 11
Посетители, находящиеся в группе Гости, не могут оставлять комментарии к данной публикации.